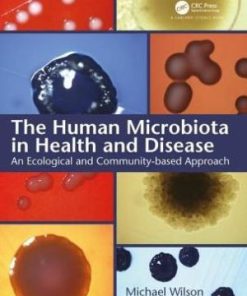
The Human Microbiota in Health and Disease An Ecological and Community based Approach
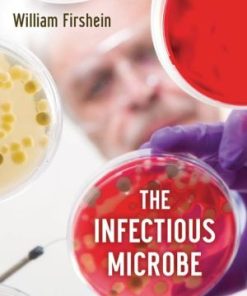
The Infectious Microbe

Shop
Showing 6508–6516 of 26071 results
Filter by price
Product categories
- Aerospace Books (225)
- Biomechanics Books (49)
- Biometrics Books (15)
- Biophysics Books (32)
- Biopolymer Books (67)
- Biostatistics Books (61)
- Biotechnology Books (373)
- Cellular and Molecular Biology Books (204)
- Clinical Science (6614)
- Hydrology and Limnology Books (102)
- Hygiene and Health Books (758)
- Immunology Books (238)
- Infectious Disease Books (70)
- Internal Medicine Books (130)
- Laboratory Sciences Books (112)
- Marine Biology and Oceanography Books (99)
- Medical Documents books (9)
- Medical Education Books (544)
- Medical Informatics Books (39)
- Metabolics Books (19)
- MRCOG Books (39)
- Nuclear Medicine books (29)
- Nutrition Books (123)
- Oncology Books (269)
- Others Health Sciences and Medicine Books (521)
- Others Life Sciences and Biology Books (285)
- Oxford Books (37)
- Paleontology Books (16)
- Parasitology Books (17)
- Parkinson Books (4)
- Plant Biology Books (109)
- Proteomics Books (19)
- Scrub (35)
- Soil Science Books (40)
- Sports Medicine Books (188)
- Stem Cells Books (46)
- Telemedicine and Health Books (27)
- Toxicology Books (68)
- Traditional Medicine Books (78)
- Tropical Medicine Books (3)
- Virology Books (43)
Showing 21691–21720 of 26071 results
-

The Human Hippocampus Functional Anatomy Vascularization and Serial Sections with MRI
Call for Price Quick View Compare -

The Human Hypothalamus Anatomy Functions and Disorders
Call for Price Quick View Compare -
Sale!

The Human Hypothalamus: Neuroendocrine Disorders
د.إ1,617.00Original price was: د.إ1,617.00.د.إ1,030.00Current price is: د.إ1,030.00. Quick View Compare -

The Human Machine
د.إ150.00 Quick View Compare -
The Human Microbiota in Health and Disease An Ecological and Community based Approach
Call for Price Quick View Compare -

The Ice Book
د.إ117.00 Quick View Compare -
Sale!

The ICU Book
د.إ807.00Original price was: د.إ807.00.د.إ768.00Current price is: د.إ768.00. Quick View Compare -

The Ideal Dental Practice Is Your Practice Personality Sabotaging Your Success
د.إ319.00 Quick View Compare -

The Illustrated History of the Elements
د.إ252.00 Quick View Compare -
Sale!

The Illustrative Book of Cartilage Repair
د.إ1,538.00Original price was: د.إ1,538.00.د.إ1,290.00Current price is: د.إ1,290.00. Quick View Compare -

The Immortal Life of Henrietta Lacks
د.إ190.00 Quick View Compare -

The Immune Synapse Methods and Protocols
د.إ820.00 Quick View Compare -

The Immune System
د.إ335.00 Quick View Compare -
Sale!

The Immune System
د.إ1,176.00Original price was: د.إ1,176.00.د.إ880.00Current price is: د.إ880.00. Quick View Compare -

The Immunity Dose
د.إ176.00 Quick View Compare -

The Immunological Basis of Asthma
Call for Price Quick View Compare -

The Immunological Synapse Part C (Volume 193)
د.إ1,029.00 Quick View Compare -

The Immunology of Cardiovascular Homeostasis and Pathology
Call for Price Quick View Compare -

The Immunology of the Cat
د.إ882.00 Quick View Compare -

The Immunology of the Dog
د.إ1,029.00 Quick View Compare -

The Immunology of the Domestic Ruminants
د.إ1,029.00 Quick View Compare -

The Impact of Nanoparticles on Agriculture and Soil
د.إ1,176.00 Quick View Compare -

The Impact of Nutrition and Statins on Cardiovascular Diseases
Call for Price Quick View Compare -

The Impact of Nutrition and Statins on Cardiovascular Diseases
Call for Price Quick View Compare -

THE INCONVENIENT TRUTH ABOUT CAVITIES Everything You Need to Know About Cavities Between Your Teeth and a Tooth Decay
د.إ183.00 Quick View Compare -

The Indian Ocean and its Role in the Global Climate System
د.إ1,058.00 Quick View Compare -
The Infectious Microbe
Call for Price Quick View Compare -

The Inflammation Cure How to Combat the Hidden Factor Behind Heart Disease Arthritis Asthma Diabetes & Other Diseases
Call for Price Quick View Compare -

The Inflammation Syndrome The Complete Nutritional Program to Prevent and Reverse Heart Disease Arthritis Diabetes Allergies and Asthma
Call for Price Quick View Compare -

The Insect Crisis – The Fall of the Tiny Empires That Run the World
د.إ117.00 Quick View Compare
Recently Viewed Products
No recently viewed products to display

